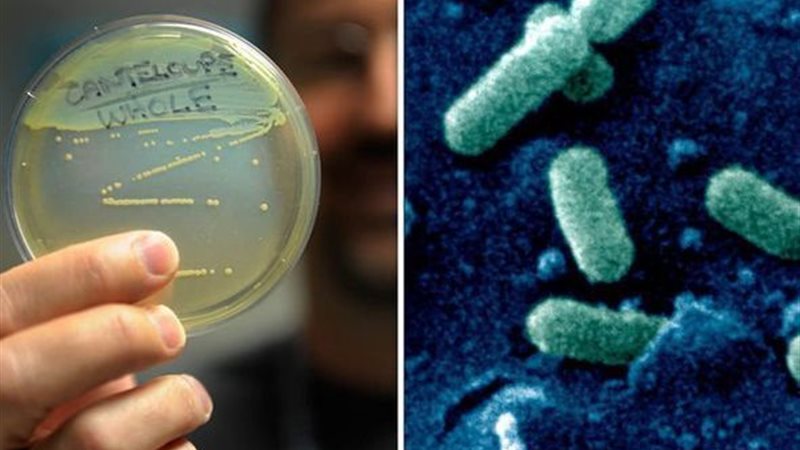

Листериоз фото
Ответы пдд для категории б
Альфа лиры 4 букв сканворд
Дюспаталин инструкция и аналоги отзывы
Алтея розовая
Не имеющим свою точку зрения
Как оплачиваются курсы
Рак неоперабельный 4 стадия
Оди перевод
Прозаический цикл
Баста zivert неболей mp3
Лекарство для продления половового
Алиса включи песни 2025 года
Сравните командную и рыночную экономическую систему
Листериоз фото 115 фотографий